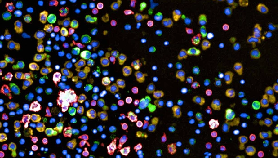

High-Throughput Testing of Hundreds of Anti-Cancer Drug Combinations

Researchers at ETH Zurich in Switzerland have developed a high-throughput screening method for anti-cancer drugs that they have called “pharmascopy”. To date, the researchers have tested the system with multiple myeloma samples, a cancer that has a poor prognosis and is difficult to treat because of drug resistance. In such cancers, finding the right drug or drug combination for a given patent is critical. The approach involves seeding the cancer cells into 384-well plates, and then placing different drugs or drug combinations into each well. After a 24 hour period of incubation, the cells can be labelled with antibodies and then imaged automatically, before AI image analysis to determine what effects the drugs have had. Leveraging the power of AI means that the whole procedure is rapid, and the results should provide a personalized treatment direction for each patient.
Multiple myeloma is a blood cancer that is particularly difficult to manage and life expectancy after diagnosis remains at an average of five years. A major problem is the tendency of the cancer to become resistant to many treatments, returning after each round of treatment and gaining resistance to multiple anti-cancer drugs. Simply flying blind and trying different drugs at random is unlikely to yield a positive outcome.
However, it can be difficult and time-consuming to test a patient’s cancer for its resistance or susceptibility to various drugs. This new technology is a high-throughput system that is designed to take some of the pain out of drug susceptibility testing, and it leverages the power of AI to do so.
The new approach is called pharmascopy, and it starts with taking a sample of the cancer. In this case, the researchers tested their system with multiple myeloma, and analyzed 138 bone marrow biopsies from 89 myeloma patients. The patients demonstrated different stages of multiple myeloma. Some of the patients had not been treated previously, whereas others had undergone multiple rounds of treatment, providing a varied pool of samples for the system.
The researchers placed the cells from the biopsies to 384 wells plates, added different combinations of drugs to different wells, and then incubated the well plates for 24 hours. They then stained the cells with antibodies before automated imaging and subsequent AI analysis.
The system allowed the researchers to quickly identify drugs or drug combinations that are likely to be beneficial for specific patients. The researchers also hope that the system can be adapted to help screen patients with other types of cancer, providing a quick turn around in the treatment journey.
Source: medgadget.com